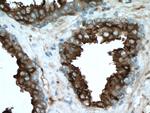
KLK3/PSA Antibody in Immunohistochemistry (Paraffin) (IHC (P))

Search
Proteintech
KLK3/PSA Monoclonal Antibody (4A1E2)
{{$productOrderCtrl.translations['antibody.pdp.commerceCard.promotion.promotions']}}
{{$productOrderCtrl.translations['antibody.pdp.commerceCard.promotion.viewpromo']}}
{{$productOrderCtrl.translations['antibody.pdp.commerceCard.promotion.promocode']}}: {{promo.promoCode}} {{promo.promoTitle}} {{promo.promoDescription}}. {{$productOrderCtrl.translations['antibody.pdp.commerceCard.promotion.learnmore']}}
产品信息
60338-1-IG
种属反应
宿主/亚型
分类
类型
克隆号
抗原
偶联物
形式
浓度
规格
纯化类型
保存液
内含物
保存条件
运输条件
产品详细信息
Immunogen sequence: MWVPVVFLT LSVTWIGAAP LILSRIVGGW ECEKHSQPWQ VLVASRGRAV CGGVLVHPQW VLTAAHCIRN KSVILLGRHS LFHPEDTGQV FQVSHSFPHP LYDMSLLKNR FLRPGDDSSH DLMLLRLSEP AELTDAVKVM DLPTQEPALG TTCYASGWGS IEPEEFLTPK KLQCVDLHVI SNDVCAQVHP QKVTKFMLCA GRWTGGKSTC SGDSGGPLVC NGVLQGITSW GSEPCALPER PSLYTKVVHY RKWIKDTIVA NP (1-261 aa encoded by BC005307)
靶标信息
PSA is a chymotrypsin-like serine protease (kallikrein family) produced by the prostate epithelium, and is abundant in seminal fluid. PSA can be detected in the sera of patients with prostatic carcinoma. It is predominantly complexed to a liver-derived serine protease inhibitor, alpha-1-antichymotrypsin (ACT). A higher proportion of serum PSA is complexed to ACT in prostate cancer than in benign prostate hyperplasia. PSA is used to confirm prostatic acinar cell origin in primary and metastatic carcinoma and to rule out non-prostatic carcinoma mimics.
仅用于科研。不用于诊断过程。未经明确授权不得转售。
生物信息学
蛋白别名: Antigen; Gamma-seminoprotein; Kallikrein 3; Kallikrein-3; Kallikrein-3 (KLK3); KLK-3; P-30 antigen; prostate specific antigen precursor; prostate-specific (APS); Prostate-specific antigen; PSA; PSA; KLK3; Semenogelase; Seminin; unnamed protein product
基因别名: APS; hK3; KLK2A1; KLK3; PSA
UniProt ID: (Human) P07288
Entrez Gene ID: (Human) 354